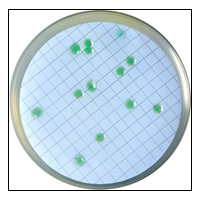

Pesadilla en la piscina

Por Andrea Alacreu Fernández, Responsable de Físico-químico, y Enedina Hurtado López, Responsable de Microbiología, en Ambientalys Consultoría y Análisis, S.L.
Las temperaturas comienzan a aumentar y el verano está a la vuelta de la esquina. Con la llegada del buen tiempo, y con el fin de aliviar los días calurosos, comienza también la temporada de baño y el uso y disfrute de las piscinas. En un post anterior, publicado por nuestro compañero Juan López, dimos a conocer la legislación aplicable a las piscinas y los parámetros a analizar.
De acuerdo al artículo 10 del Real Decreto 742/2013 “el agua del vaso deberá estar libre de organismos patógenos y de sustancias en una cantidad o concentración que pueda suponer un riesgo para la salud humana”. Trataremos, en este post de indicaros dos de los casos más frecuentes de incumplimiento de este artículo: presencia de Pseudomonas aeruginosa y valores elevados de ácido isocianúrico, e intentaremos daros algunas pautas a seguir para que el control de tu piscina no se convierta en una pesadilla, teniendo siempre en cuenta que se trata de consideraciones generales en el tratamiento de aguas, y que cada caso particular puede requerir de medidas específicas.
Ácido Isocianúrico (valor paramétrico: 75 mg/ L)
El ácido isocianúrico es un subproducto que se forma a partir de derivados del ácido cianúrico. Se utiliza en piscinas que son desinfectadas con cloro, y más concretamente aquellas que emplean pastillas de cloro u otros formatos cuyo estabilizante es el ácido tricloroisocianúrico (cloroisocianurados o cloros orgánicos) y su función es evitar que los rayos UV del sol destruyan el cloro residual.
El ácido tricloroisocianúrico se descompone lentamente, formando el ácido hipocloroso (cloro residual) que actuará como desinfectante en la piscina combinándose con la materia orgánica, y dejando ácido isocianúrico como residuo:

El cloro es temporal por su naturaleza, y por ello hay que ir dosificando más a medida que pasa el tiempo. Pero a diferencia de lo que se puede creer, cada vez que dosificamos estas pastillas a la piscina, la concentración de ácido isocianúrico aumenta; de esta forma este ácido se acumula, el pH del agua disminuye e impide que el ácido hipocloroso actúe eficazmente sobre los microorganismos. A fin de acortar esta carga progresiva de subproductos de la desinfección, la mayoría de reglamentaciones autonómicas sobre piscinas (Decreto 80/1998 Comunidad de Madrid, Decreto 58/1992 Región de Murcia, Decreto 95/2000 de Cataluña…) prevén al menos un vaciado anual. Pero, ¿qué hacer si el resultado analítico nos indica que el ácido isocianúrico es superior a 75 mg/L? La solución más radical es vaciar la piscina de forma parcial o total. Otra de las soluciones es, mediante dosificación de melamina (C3H6N6), formar un complejo no soluble de ácido isocianúrico-melamina fácilmente eliminable por filtración. Finalmente podemos decantarnos por otro método de desinfección, y sustituir los derivados de ácido tricloroisocianúrico por cloro inorgánico, bromo (muy utilizado en piscinas cubiertas) u oxígeno activo.
Pseudomonas aeruginosa (valor paramétrico: 0 ufc/ 100 mL)
Cuando la desinfección del agua de la piscina no es adecuada (ya sea porque el desinfectante residual es insuficiente, porque el pH no sea adecuado, o porque haya un exceso de ácido isocianúrico) el uso y disfrute de la piscina puede suponer la aparición de una serie de consecuencias (más o menos graves) en la salud de los usuarios, y en muchos de estos casos, existe un denominador común, la Pseudomonas aeruginosa, una bacteria oportunista que “hace su agosto durante el verano”.
Pseudomonas aeruginosa es una bacteria ampliamente distribuida en el ambiente. Es habitual encontrarla en suelos, aguas naturales de lagos y ríos y en aguas potables en bajas concentraciones, si bien puede llegar a la piscina transportada por los propios bañistas en boca, oídos y otras zonas corporales húmedas y habitualmente sudorosas como axilas, ombligo, ingles y periferia del ano. Algunas especies sintetizan una capa de exopolisacáridos que la hace más resistente a los desinfectantes, y facilita la adhesión celular y formación de biofilms que los protege de la fagocitosis y aumenta su patogenicidad. En piscinas es frecuente encontrarla en la superficie del agua, los bordes del vaso o los skimmers donde se nutre de residuos grasos de leches corporales, bronceadores y protectores solares que forman una biopelícula en la lámina superior de agua.
Aunque las infecciones habituales por Pseudomonas aeruginosa asociadas a ambientes acuáticos no suelen revestir gravedad, su presencia en el agua de la piscina se asocia con:
- Otitis externa (otitis del nadador): la humectación de la piel al ducharse aumenta la maceración de la piel del conducto auditivo externo y crea un entorno favorable para el crecimiento bacteriano.
- Foliculitis (dermatitis): ronchas en la piel que causan picazón y que se convierten en una erupción elevada de color rojizo.
- Conjuntivitis: molestias en los párpados, enrojecimiento del ojo, picor o sensación de cuerpo extraño (arena), secreciones acuosas, mucosas o muco-purulentas que pueden llegar a pegar los párpados al despertar por las mañanas.
Las pautas generales a seguir en caso de detectar recuentos de Pseudomonas aeruginosa en el agua del vaso de la piscina incluyen la limpieza y rascado de skimmers y bordes del vaso para eliminar el biofilm, la renovación del agua de la superficie del vaso y la hipercloración.
A pesar de realizar estas actuaciones, a menudo nos encontramos con instalaciones con recuentos elevados de Pseudomonas aeruginosa de manera recurrente, esto puede ser debido a:
- Cloración de choque insuficiente: en ocasiones, tratamientos de choque de 20 mg/L no es suficiente para inactivarla o minimizar su concentración.
- Recirculación no correcta del agua por la existencia de “zonas muertas” en piscinas en las que el vaso tiene ángulos, recodos u obstáculos.
- Contaminación de los filtros de arena, prefiltros….
- Superficies rugosas y de difícil limpieza y desinfección que favorecen la incrustación de la suciedad y la formación de biofilms.
Con estos consejos y recomendaciones, evitaremos parte de los riesgos sanitarios derivados de la presencia de contaminantes biológicos y químicos en el agua de la piscina.
En Ambientalys, apostamos por el tratamiento de aguas de piscinas en la época de verano que ya llega, pero ofrecemos este servicio todo el año.



